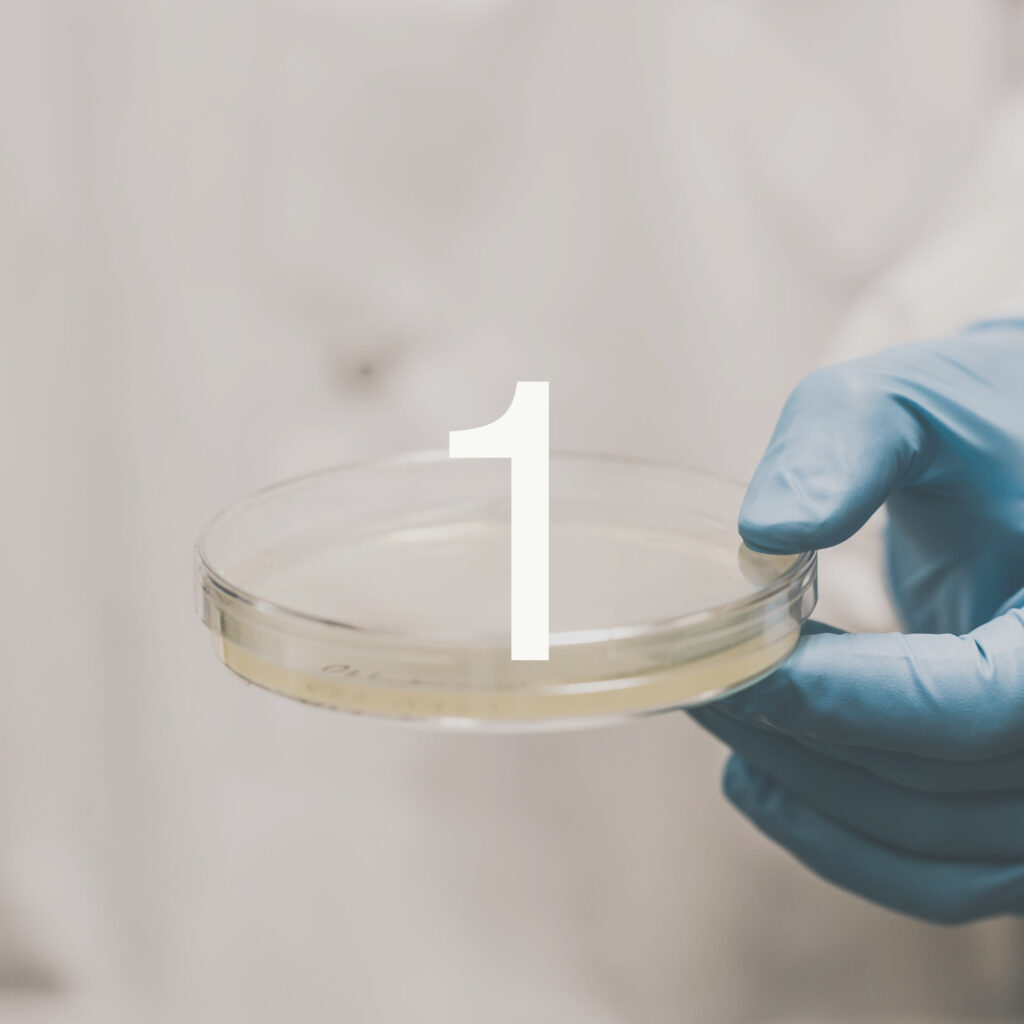

Podcast Seasons
Latest Season
Season 8 Where Cultures Collide
Meet at a crossroads of cultures—past and present—in search of humanity’s collective destination.
Open SeasonRecent Episodes
Past Seasons
Season 7
Since the dawn of our species, the ability to make things has made us who we are. Anthropologists look at how a wide range of technologies—from smartphones to comic books to cooking to hydroelectric dams—are intertwined with our lives.

Season 6
In this eight-part series, a famed anthropologist’s controversial research in American Samoa reveals the biggest questions about growing up and being human.

Season 5
Being human is complicated. We require food and shelter. We have histories to contend with. We create rituals to control fate. We steal. We fight. We kill. We love. Join host Eshe Lewis, on our latest journey to explore what it means to be human through the lens of anthropology.

Season 4
Hosts Ora Marek-Martinez and Yoli Ngandali share the stories of Black and Indigenous people who become archaeologists. From defying the status quo to diving through sunken ships, this special season brings listeners on a journey of reclaiming voices and reimagining history.

Season 3
In early 2020, the COVID-19 pandemic struck humanity. The SAPIENS podcast explores anthropological insights into what this crisis taught humanity about our evolution, how we deal with abstract threats, love and resilience in hard times, and much more.

Season 2
Why can eating insects be so gross? Who were the ancient Denisovans? How are dreams shaped by culture? Are people naturally generous? The SAPIENS podcast is back, exploring an array of curious questions about the human experience.

Season 1
What makes you … you? Is it your DNA, culture, environment? SAPIENS hosts Esteban Gómez, Jen Shannon, and Chip Colwell speak with anthropologists from around the globe to help us uncover what makes us human.